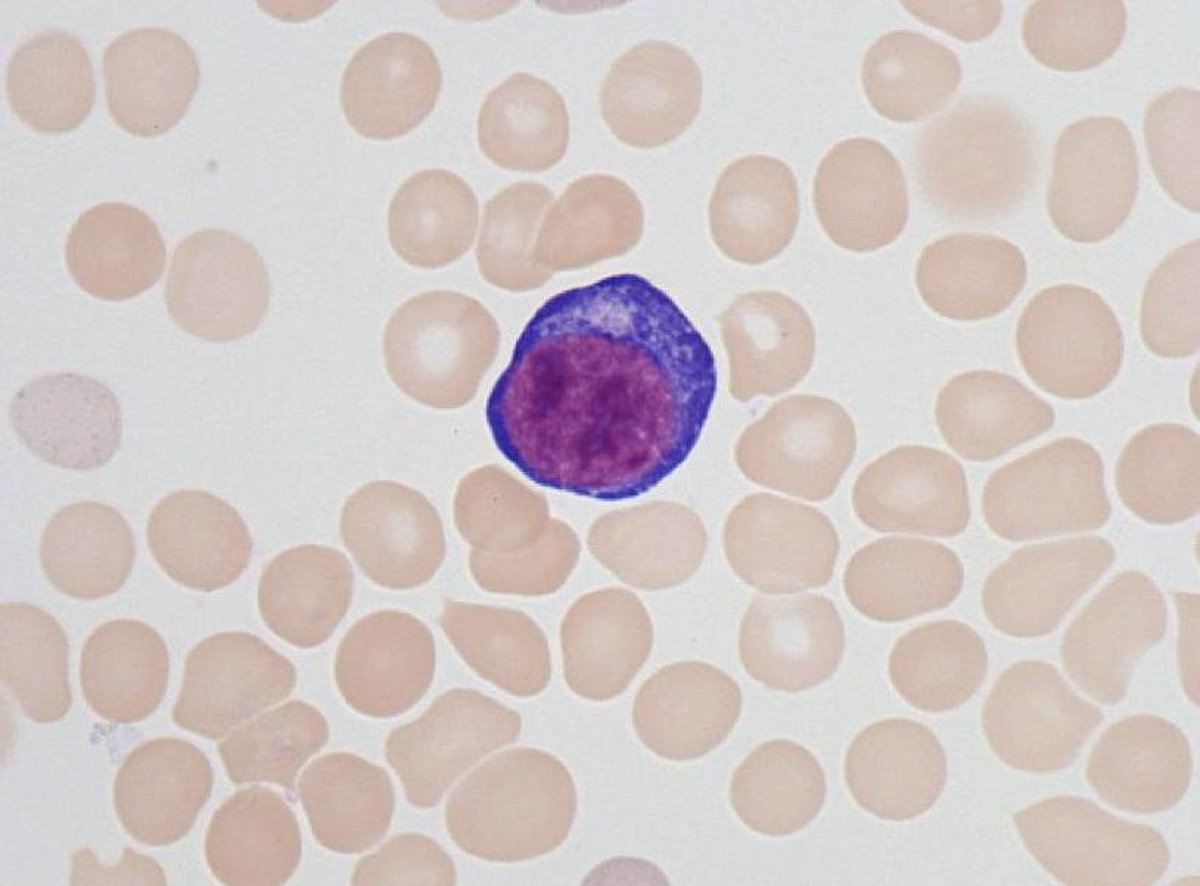
Proerythroblast

Proerythroblast
- Size : 20 µm
- Normal values : Absent in the blood
- Description / Pathology :
Round cell of 20µm, round nucleus with fine chromatin, the cytoplasm is intensely basophilic. The nuclear-cytoplasmic ratio is elevated.
Round cell of 20µm, round nucleus with fine chromatin, the cytoplasm is intensely basophilic. The nuclear-cytoplasmic ratio is elevated.